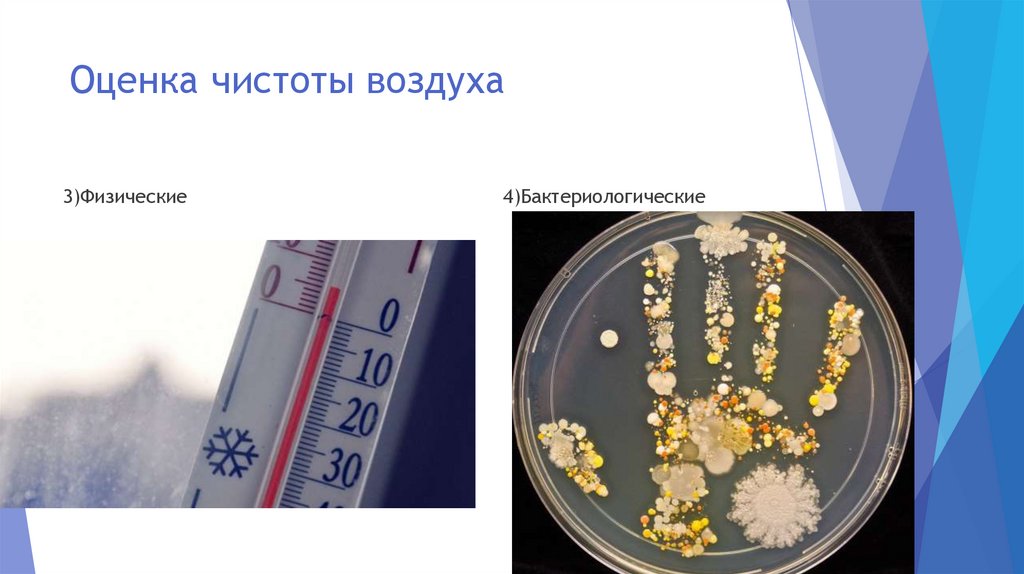
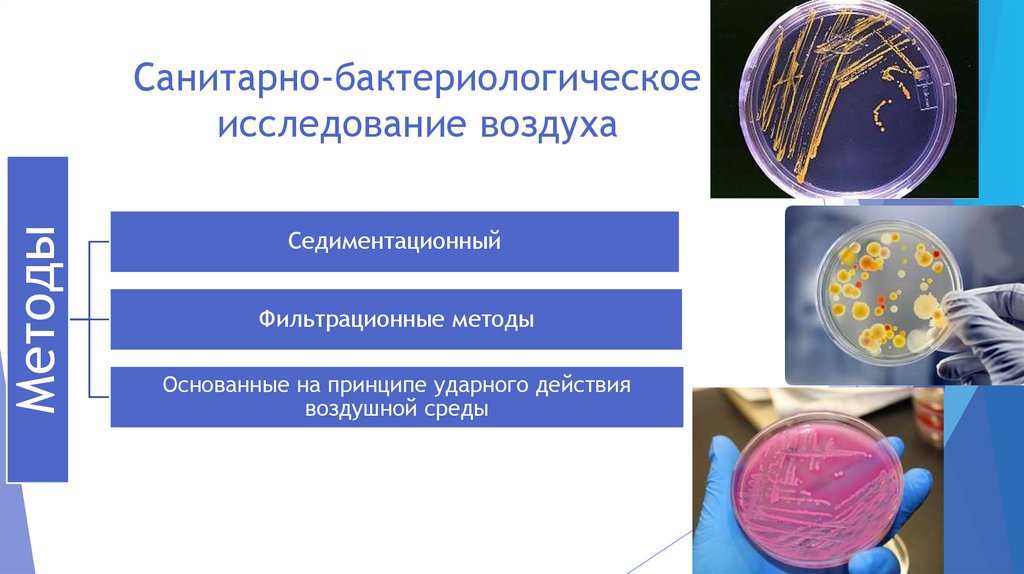

Similar presentations:
Воздушная среда и вентиляция
1.
Воздушная среда ивентиляция
Подготовила студентка 272 группы Хмелевских А.В.
2.
Воздух открытойатмосферы
Производственные
процессы
Человек
Комнатная
пыль
Воздух
закрытых
помещений
От приборов
Полимерные и другие
вещества
Случайные
3.
Фёдор Фёдорович Эрисман4.
Оценка чистоты воздуха:1)Органолептические
2)Химические
5.
Оценка чистоты воздуха3)Физические
4)Бактериологические
6.
Экспресс метод определения СО27.
8.
МетодыСанитарно-бактериологическое
исследование воздуха
Седиментационный
Фильтрационные методы
Основанные на принципе ударного действия
воздушной среды
9.
Аппарат КротоваПринцип работы аппарата Кротова основан на
том, что воздух, просасываемый через
клиновидную щель в крышке аппарата,
ударяется о поверхность питательной среды,
при этом частицы пыли и аэрозоля прилипают к
среде, а вместе с ними и микроорганизмы,
находящиеся в воздухе. Чашку Петри с тонким
слоем среды укрепляют на вращающемся
столике аппарата, что обеспечивает
равномерное распределение бактерий на ее
поверхности. Работает аппарат от электросети.
Обычно отбор проб проводят со скоростью 2025 л/мин
10.
ВентиляцияВентиляция
Естественная
Искусственная
11.
Приточно-вытяжная вентиляцияПриточно-вытяжная
вентиляция
одновременно подает
чистый воздух и удаляет
загрязненный. Обычно
воздух по притоку
обозначается знаком (+),
по вытяжке - знаком (-).

Construction
Construction








